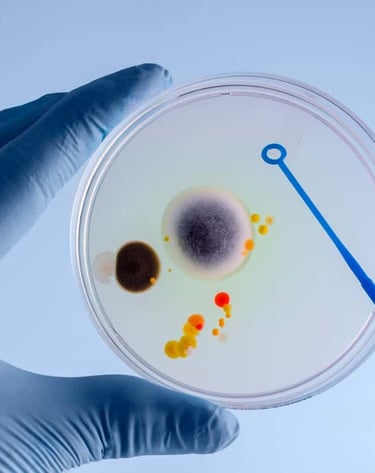
Análisis RAM - plantas de agua purificada - Recuento de Organismos Aerobios Mesofilos
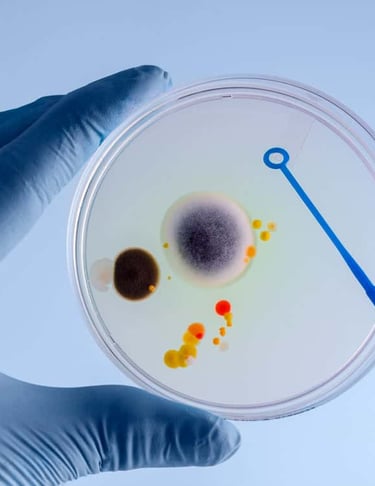
Análisis RAM - plantas de agua purificada - Recuento de Organismos Aerobios Mesofilos

Hacemos un seguimiento al proceso de producción adaptándonos al tamaño de tu planta. Verificamos el buen funcionamiento y la continuidad de la calidad de esta. Los datos de las mediciones y análisis se utilizan para este fin y son tomados y guardados en bases de datos para la fácil trazabilidad de estos y posible presentación a la autoridad sanitaria. Junto a esto, entregamos una web externa linkeable a través de un código QR para que el consumidor, tú cliente, pueda fácilmente conocer la calidad de tu agua y la seriedad de tu planta.
Plantas de agua Purificada (mantenimiento de calidad)
Diferénciate de tu competencia.
Calidad no es cantidad
Revisa nuestros planes abajo y ve cual se ajusta al tamaño de tu planta y tus requerimientos. No olvides leer las condiciones.


*Plan central
✔ Verificación de calidad del agua mensual
❌ Revisión de la eficiencia
✔ Análisis Microbiológico y RAM mensual
✔ Informe mensual
✔ web de verificación x 6 meses
$ 90.000 + IVA /mes
*Plan activa
✔ Verificación de calidad del agua mensual
✔ Revisión de la eficiencia de procesos quincenal
✔ Análisis Microbiológico y RAM mensual
✔ Informe mensual
✔ web de verificación x 6 meses
$ 195.000 + IVA /mes
*Plan EXURA
✔ Verificación de calidad del agua mensual
✔ Revisión de la eficiencia acordado
✔ Análisis Microbiológico y RAM mensual
✔ Informe mensual
✔ web de verificación x 6 meses
$ 290.000 + IVA /mes
Nuestros Planes








Calidad del agua.
Se genera informe in situ con el registro de datos de los parámetros medidos en el punto final, producto envasado.

Eficiencia del Sistema.
Medición de parámetros críticos en puntos prestablecidos del proceso productivo. se genera informe in situ con el registro de datos medidos.
Análisis Microbiológico
Ensayo bacteriológico del producto terminado en laboratorio inscrito INN. Coliformes, Coliformes Fecales y Recuento de Aerobios Mesófilos (Análisis RAM).
Informe
Análisis de datos acumulados y recomendaciones de mejoramiento de eficiencia, posibles acciones a emprender.


Entregamos a tus consumidores la información de tu agua en nuestra propia plataforma web. Esto da a tu marca mucha mayor transparencia y a tus clientes seguridad...
A través de un código QR, que puedes imprimir en tus etiquetas, los clientes pueden verificar en una web nuestra, certificados e informes de laboratorio y cerciorarse de que consumen un agua segura y de calidad.
Verificación Web
Sobre el procedimiento
En el esquema se resume el procedimiento bajo los términos y condiciones para la planta de ósmosis inversa / agua purificada.
Comenzamos con la revisión de la Resolución Sanitaria del Ministerio de Salud y documentación de la SEREMI de Salud, si corresponde. Se realizan los análisis correspondientes. De estar todo en orden se procede a la elección del plan y la implementación de la web de verificación.




